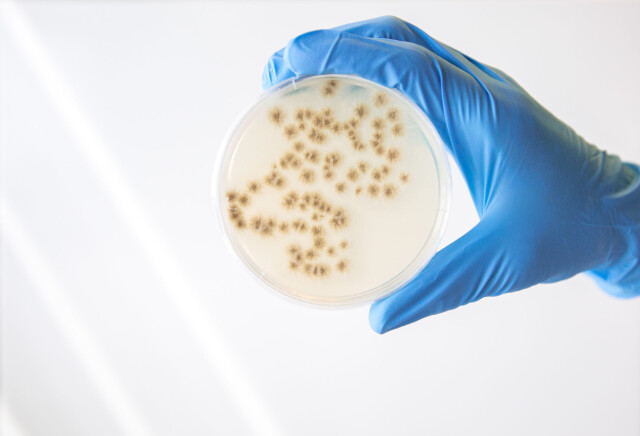

– Verdens første fisk oppdrettet på mykoprotein
Det er påstanden fra selskapet Cirkulär i Lund, Sverige. De er en av aktørene i prosjektet «Framtidens foder», som har oppdrettet og solgt fisk uten bruk av fiskemel for kommersielt salg. Nå er Cirkulär i dialog med norske fôrprodusenter.
Ifølge dem er det altså første gang fisk oppdrettet på mykoprotein har nådd markedet. Proteinet er laget av gjærceller som har spist på avfall fra skogindustrien.
Sentralt i dette står selskapet Cirkulär fra Lund, som omdanner industrielle sidestrømmer fra skogindustrien til høyverdige, sirkulære basisingredienser.
Etter å ha drevet et pilotanlegg i Sør-Sverige de siste to årene, tar selskapet nå neste steg mot et fullskala produksjonsanlegg.
Produksjon av fisk basert på mykoprotein adresserer to globale utfordringer: fiskefôrindustriens avhengighet av soya og fiskemel, og skogindustriens behov for sirkulære løsninger for sine sidestrømmer.
Initiativet er en del av «Fremtidens Fôr», ledet av Axfoundation og Sveriges landbruksuniversitet (SLU), sammen med flere aktører gjennom hele verdikjeden.

Fra validering til kommersiell virkelighet
Siden 2023 har Cirkulär drevet en pilotfabrikk i industriell skala i Skåne. altså mykoproteinet lages og bioproduksjonsprosessen har blitt grundig validert. Ved hjelp av en egenutviklet sopp- og fermenteringsteknologi, mates soppkulturen med sidestrømmer fra skogindustrien og omdanner disse til en sirkulær proteinmasse som er ideell som fiskefôr, sier han videre.

– Anlegget har vist stabil ytelse og beviser nå at sirkulære proteiner kan produseres pålitelig i større skala, melder selskapet. Dette gjennombruddet viser at teknologien vår ikke bare er robust, men også kommersielt levedyktig, sier Eric Öste, administrerende direktør og grunnlegger av Cirkulär.
Fisken de har produsert er regnbueørret oppdrettet i Älvdalen av selskapet Älvdalslax.
– Vi kaller den Fremtidens fisk, og den er en del av det Vinnova-finansierte prosjektet «Framtidens Foder för Fågel, Fisk och Fläsk», der målet er å erstatte soya og fiskemel med mykoprotein (samt insektmel og blåskjellmel), som er betydelig mer bærekraftige i alle ledd, forteller adm.dir. Eric Öste til LandbasedAQ.
Han forteller fisken hadde en gjennomsnittsvekt på 4,1 kg da man startet utslakting.
– Så langt er det levert 2,4 tonn av totalt om lag 6 tonn som skal leveres i denne første runden, sier han.



I dialog med norske aktører
– Hvem ser dere på som potensielle kunder for mykoproteinet?
– For øyeblikket har vi fullt fokus på fiskefôrindustrien, hvor den norske industrien naturligvis har høyeste prioritet, som verdens største marked. Vi er for tiden i dialog med flere norske produsenter, avslører han.
Fisken selges nå i utvalgte Hemköp-butikker (svensk dagligvarekjede), samt serveres på Urban Deli (svensk restaurantkjede) og via Fiskhallen Sorunda (foodservice) til utvalgte restauranter i Stockholm og Gøteborg.
– Har dere gjort noen parallelle studier av fisken og fiskehelsen?
– Ja. Sensoriske tester utført av eksperter ved Grythyttan viste at regnbueørret oppdrettet på Fremtidens fôr smaker like godt som fisk fôret med tradisjonelt fôr.
Öste forteller at «Fremtidens fisk» ble beskrevet som å ha «en frisk smak med nøttaktige og mineralske toner, samt en god tekstur som var myk, lett saftig og smeltet i munnen».
– Fisken holder like høy kvalitet som fisk oppdrettet på vanlig fôr – og den vokser like bra. For oppdretterne betyr dette både nye forretningsmuligheter og et aktivt bidrag til det grønne skiftet, mener han.

Oppskalerer
Og med med en validert prosess og et første produkt ute på markedet, går Cirkulär nå videre mot fullskala anlegg med kapasitet på titusenvis av tonn årlig.
– I tillegg til å møte utfordringene i fiskefôrindustrien er målet å levere ingredienser til en rekke ulike bransjer – fra dyrefôr og mat til hudpleie og biostimulanter, sier Öste.
Mer informasjon om «Fremtidens fisk» finnes her:
https://www.axfoundation.se/nyheter/varldens-forsta-fisk-uppfodd-med-mykoprotein-svensk-satsning-bakom-framtidens-foder
🔗
https://www.axfoundation.se/en/projects/feed-of-the-future
(scroll ned til Framtidens fisk).
ANNONSØRARTIKLER
-

Fra pålitelig overvåking til smart styring
-

Intelligente kamerasystemer, utviklet spesielt for landbasert oppdrett
-

Fra krevende maritime operasjoner til fremtidens landbaserte oppdrett
-

Utslippskravene strammes til – slik får du full kontroll
-

Når strømmen stopper i oppdrett
-

Presis UV-dosering reduserer biologisk risiko i landbasert oppdrett
-

Derfor mener vi du skal bruke slike filtre
-

KROHNEs instrumenter er helt sentral i produksjonen
-

Revolusjon i RAS: Skivefiltrenes gjennombrudd
-

Er ditt RAS-anlegg godt rustet mot brann?





















